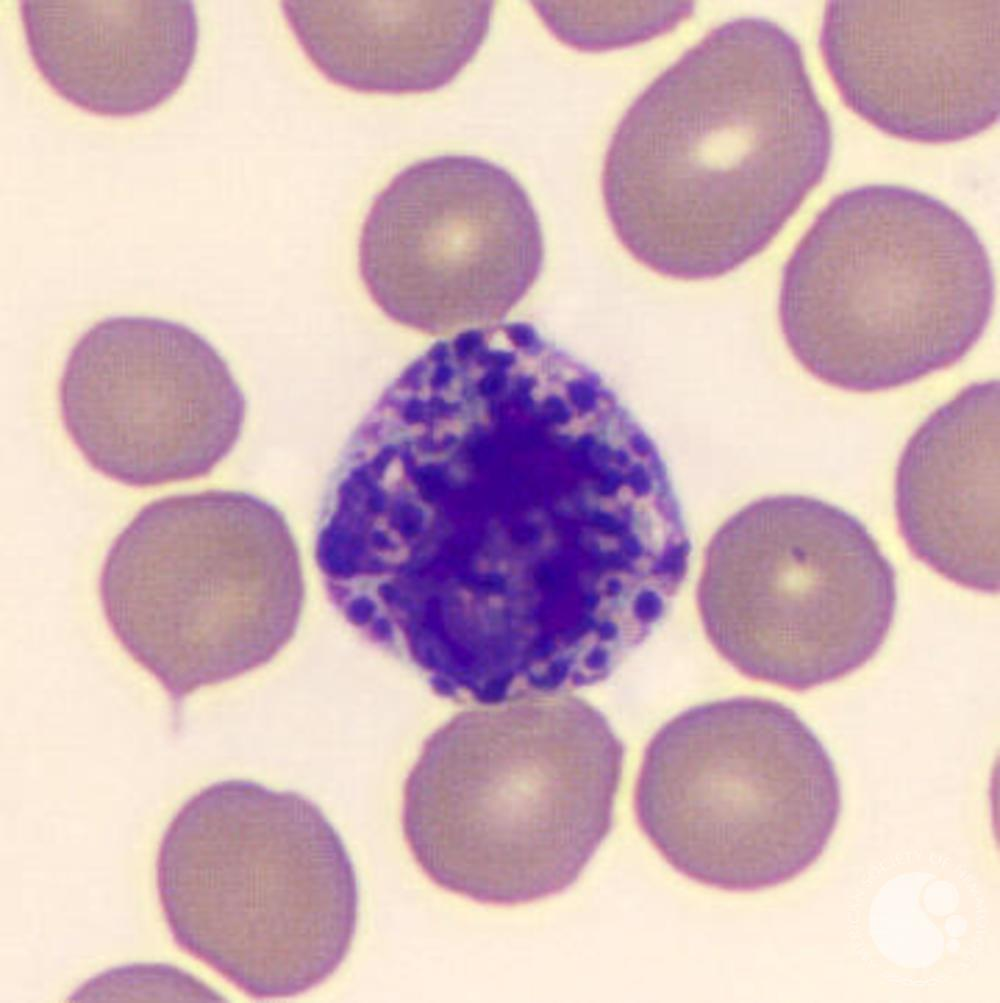
knowt flashcard image
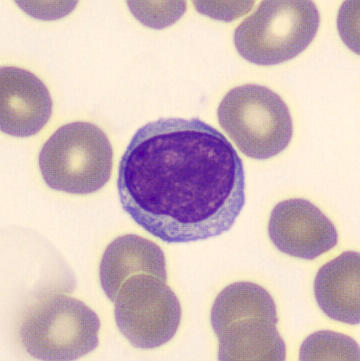
knowt flashcard image

BIOL 133 Lab Histology
0.0(0)
0.0(0)
Card Sorting
1/4
There's no tags or description
Looks like no tags are added yet.
Study Analytics
Name | Mastery | Learn | Test | Matching | Spaced | Call with Kai |
|---|
No study sessions yet.
5 Terms
1
New cards
neutrophils

2
New cards
eosinophils

3
New cards
basophils
4
New cards
lymphocytes
5
New cards
monocytes
